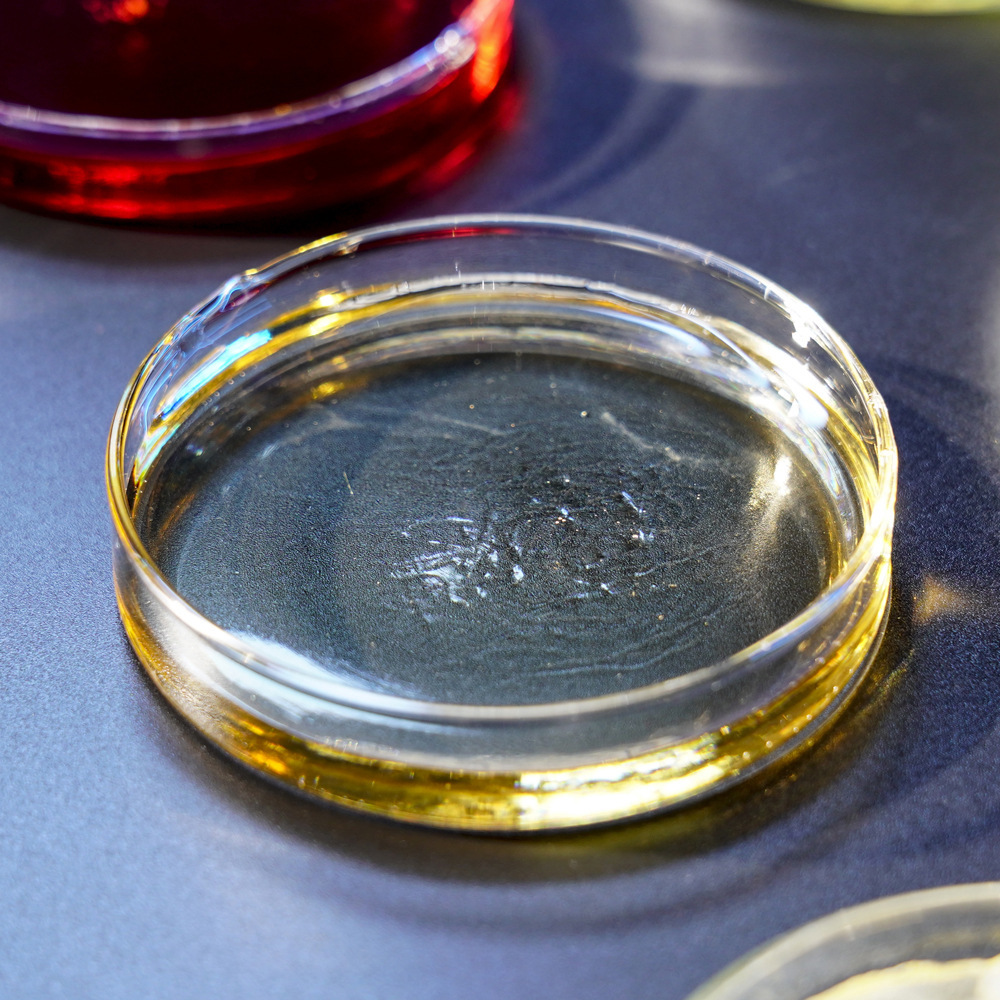
DCPD型苯并噁嗪樹脂 DCPD型苯并噁嗪樹脂

聯苯芳烷基酚醛樹脂
-
 聯苯芳烷基酚醛樹脂聯苯芳烷基酚醛樹脂是一種(zhǒng)熱固性樹脂,具有優異的耐熱性、耐腐蝕性和機械性能(néng)。它具有良好(hǎo)的絕緣性能(néng),能(néng)夠抵抗高溫、高濕和化學(xué)腐蝕。此外,聯苯芳烷基酚醛樹脂還(hái)具有較好(hǎo)的耐磨性和耐燃性,能(néng)夠滿足各種(zhǒng)特殊工藝和使用要求。
聯苯芳烷基酚醛樹脂聯苯芳烷基酚醛樹脂是一種(zhǒng)熱固性樹脂,具有優異的耐熱性、耐腐蝕性和機械性能(néng)。它具有良好(hǎo)的絕緣性能(néng),能(néng)夠抵抗高溫、高濕和化學(xué)腐蝕。此外,聯苯芳烷基酚醛樹脂還(hái)具有較好(hǎo)的耐磨性和耐燃性,能(néng)夠滿足各種(zhǒng)特殊工藝和使用要求。
-

雙酚A二苯醚型雙馬來酰亞胺樹脂
雙酚A二苯醚型雙馬來酰亞胺樹脂雙酚A二苯醚型雙馬來酰亞胺樹脂是一種(zhǒng)廣泛應用于化學(xué)工業和材料領域的重要材料。它具有很高的熱穩定性、機械強度和耐腐蝕性能(néng),并且可通過(guò)調整配方進(jìn)行多種(zhǒng)功能(néng)的定制。
-

塗料增韌用二甲苯甲醛樹脂
塗料增韌用二甲苯甲醛樹脂塗料增韌用二甲苯甲醛樹脂是一種(zhǒng)能(néng)夠增加塗料韌性、改善塗料性能(néng)的樹脂。它具有良好(hǎo)的增塑、增韌作用,能(néng)夠增加塗料的粘接強度、改進(jìn)光澤、降低成(chéng)本。
-

礦棉用酚醛樹脂
礦棉用酚醛樹脂礦棉用酚醛樹脂是一種(zhǒng)專爲礦棉生産而設計的樹脂。這(zhè)種(zhǒng)樹脂主要用于提高礦棉制品的憎水性能(néng)和結合強度。
-

幹式料用酚醛樹脂
幹式料用酚醛樹脂幹式料用酚醛樹脂是一種(zhǒng)專爲幹式料生産而設計的樹脂。這(zhè)種(zhǒng)樹脂主要用于耐火材料的制造,如耐火磚、耐火泥漿、耐火塗料等。它具有高度的耐火性和熱穩定性,能(néng)夠在高溫環境下保持穩定的化學(xué)性質和物理性質。
-

滑闆用酚醛樹脂
滑闆用酚醛樹脂滑闆用酚醛樹脂是一種(zhǒng)熱固性樹脂,主要用于制作滑闆的耐磨層。這(zhè)種(zhǒng)樹脂具有較高的硬度、耐磨性和耐水性,能(néng)夠滿足滑闆在各種(zhǒng)地面(miàn)和環境下的使用要求。
-

鐵包磚用酚醛樹脂
鐵包磚用酚醛樹脂鐵包磚用的酚醛樹脂是一種(zhǒng)熱固性樹脂,可以在高溫下固化。這(zhè)種(zhǒng)樹脂主要用于保護鐵材料不受氧化、腐蝕等環境影響,同時(shí)能(néng)夠提高鐵材料的硬度和密度,使其更具有耐用性和承重力。
-

濾紙用酚醛樹脂
濾紙用酚醛樹脂濾紙用酚醛樹脂是一種(zhǒng)特殊的樹脂,主要應用于各種(zhǒng)工業濾紙的制作,包括空氣濾紙、機油濾紙、燃油濾紙等其他特殊行業領域用濾紙。這(zhè)種(zhǒng)樹脂能(néng)夠滿足濾紙的硬挺度、抗拉度以及耐水性等各方面(miàn)性能(néng)要求。
-

浸漬棉布用酚醛樹脂
浸漬棉布用酚醛樹脂浸漬棉布用酚醛樹脂是一種(zhǒng)特殊的酚醛樹脂,用于浸漬棉布以提高其機械強度、電性能(néng)和耐熱性能(néng)。這(zhè)種(zhǒng)酚醛樹脂通常具有較高的粘度,能(néng)夠充分滲透到棉布的纖維間隙中,形成(chéng)一層堅固的樹脂膜。
-

鋼背粘接用酚醛樹脂
鋼背粘接用酚醛樹脂在鋼背粘接應用中,酚醛樹脂可以作爲粘合劑使用。它具有優異的粘接性能(néng)和耐熱性能(néng),能(néng)夠在高溫下保持良好(hǎo)的粘接強度。此外,它還(hái)具有良好(hǎo)的耐酸性和耐堿性,能(néng)夠在惡劣的環境下保持穩定的性能(néng)。因此,酚醛樹脂是一種(zhǒng)理想的鋼背粘接材料。
-

聚合多胺型馬來酰亞胺樹脂
聚合多胺型馬來酰亞胺樹脂聚合多胺型馬來酰亞胺系列産品是一種(zhǒng)馬來酰亞胺聚合物,具有不同軟化點,可溶解于丙酮、DMF等溶劑中,下遊産品 應用過(guò)程中穩定性好(hǎo),得到的産品韌性好(hǎo)、性能(néng)優異。
-

四官能(néng)環氧樹脂
四官能(néng)環氧樹脂四官能(néng)環氧樹脂是指分子中含有四個官能(néng)團的環氧樹脂,一般具有較高的化學(xué)活性、粘附力、柔韌性、耐腐蝕等特點。
-

二聚酸改性柔韌性環氧樹脂
二聚酸改性柔韌性環氧樹脂二聚酸改性柔韌性環氧樹脂是一種(zhǒng)工業中間體,具有高粘度、粘附力強、柔韌性好(hǎo)、穩定性高、耐腐蝕等特點。
-

砂布用酚醛樹脂
砂布用酚醛樹脂砂布用酚醛樹脂是由苯酚和甲醛在堿性或酸性催化劑作用下縮聚而成(chéng)的高分子化合物,根據不同的用途可以分爲不同的種(zhǒng)類,其中砂布砂帶專用水溶性耐熱級酚醛樹脂是一種(zhǒng)常見的酚醛樹脂類型,主要用于制作砂布砂帶。
-

戶外重組材用/室内重組材用酚醛樹脂
戶外重組材用/室内重組材用酚醛樹脂戶外重組材用酚醛樹脂是一種(zhǒng)以酚類化合物與醛類化合物經(jīng)加成(chéng)反應和縮聚反應而制得的一大類合成(chéng)樹脂。
-

礦機填充發(fā)泡用酚醛樹脂
礦機填充發(fā)泡用酚醛樹脂礦機填充發(fā)泡用酚醛樹脂是一種(zhǒng)雙液型高分子注漿産品,由樹脂和催化劑組成(chéng)。該産品适用于井下有害氣體的快速堵截、封堵圍岩裂隙、構築密閉牆及防火牆、中空填充及巷道(dào)、充瓦斯抽排巷、高位鑽場及密閉、即時(shí)發(fā)泡、無火焰蔓延,還(hái)可用于滅火措施。
-

矽酸鋁棉用脲醛樹脂
矽酸鋁棉用脲醛樹脂矽酸鋁棉用脲醛樹脂是一種(zhǒng)矽酸鋁棉與脲醛樹脂混合使用的材料。這(zhè)種(zhǒng)材料通常用于保溫、隔熱、隔音等建築領域。
-

DCPD型苯并噁嗪樹脂
DCPD型苯并噁嗪樹脂DCPD型苯并噁嗪樹脂是一種(zhǒng)新開(kāi)發(fā)的新型類酚醛樹脂,它是以酚類化合物、醛類和胺類化合物爲原料合成(chéng)的一類含雜環結構的中間體。 DCPD型苯并噁嗪樹脂的制備方法是將(jiāng)DCPD與雙酚單體和催化劑A經(jīng)加熱反應形成(chéng)DCPD雙酚樹脂,再將(jiāng)DCPD雙酚樹脂與多聚甲醛,伯胺及催化劑B進(jìn)一步反應,即得到DCPD雙酚型苯并噁嗪樹脂。
-

高純酚醛型苯并噁嗪樹脂
高純酚醛型苯并噁嗪樹脂高純酚醛型苯并噁嗪樹脂是一種(zhǒng)新開(kāi)發(fā)的新型類酚醛樹脂,它是以酚類化合物、醛類和胺類化合物爲原料合成(chéng)的一類含雜環結構的中間體。高純酚醛型苯并噁嗪樹脂具有較高的熱變形溫度和耐高溫性能(néng),并且制造工藝簡單、原料充足,因而被大量應用于酚醛泡沫塑料的生産中。
-
烯丙基胺型苯并噁嗪樹脂
烯丙基胺型苯并噁嗪樹脂苯并噁嗪樹脂是一種(zhǒng)吸水率低、模量高、固化過(guò)程無小分子釋放、收縮率極低的熱固性樹脂,聖泉已經(jīng)形成(chéng)了以分子結構設計、關鍵過(guò)程控制技術爲核心的自主創新的苯并噁嗪樹脂技術體系,形成(chéng)了多個不同化學(xué)結構不同規格的系列産品。
-

MDA型苯并噁嗪樹脂-ODA型苯并噁嗪樹脂
MDA型苯并噁嗪樹脂-ODA型苯并噁嗪樹脂苯并噁嗪樹脂是一種(zhǒng)吸水率低、模量高、固化過(guò)程無小分子釋放、收縮率極低的熱固性樹脂,聖泉已經(jīng)形成(chéng)了以分子結構設計、關鍵過(guò)程控制技術爲核心的自主創新的苯并噁嗪樹脂技術體系,形成(chéng)了多個不同化學(xué)結構不同規格的系列産品。
-

礦棉裝飾吸聲闆用酚醛樹脂
礦棉裝飾吸聲闆用酚醛樹脂礦棉裝飾吸聲闆是一種(zhǒng)健康環保、可循環利用的綠色建築材料。酚醛樹脂在礦棉裝飾吸聲闆中主要起(qǐ)增加強度、降低吸水率、提高耐熱性能(néng)、防腐、防蟲、防火等作用。
-

搗打料用酚醛樹脂
搗打料用酚醛樹脂搗打料用酚醛樹脂是一種(zhǒng)熱固性酚醛樹脂,具有耐磨、耐高溫、耐腐蝕等特性,主要用于搗打料、鐵溝襯等。 搗打料用酚醛樹脂的存放周期一般爲3個月,冬天爲6個月,過(guò)期後(hòu)不能(néng)使用。搗打料用酚醛樹脂的加入量一般爲15%的骨料和粉,過(guò)高或過(guò)低都(dōu)會(huì)影響使用效果。
-

鋁鎂碳磚用酚醛樹脂
鋁鎂碳磚用酚醛樹脂鋁鎂碳磚用酚醛樹脂是一種(zhǒng)熱固性液體酚醛樹脂。它的特點爲流動性、浸潤性好(hǎo),保濕性高,氣味小,強度高,粘度适中,殘碳量高,産品加入量2.6-3.0
-

中間包用酚醛樹脂
中間包用酚醛樹脂中間包用酚醛樹脂是一種(zhǒng)耐火材料,主要用于鋼鐵行業的連鑄工藝中,可以起(qǐ)到保護鋼水和提高鋼水質量的作用。
-

水口用酚醛樹脂
水口用酚醛樹脂水口用酚醛樹脂具有可塑性好(hǎo)、殘碳量高、遇熱後(hòu)水口顯氣孔率低、粘附強度高、穩定性好(hǎo)等諸多優點,可以延長(cháng)出鐵時(shí)間,減少出鐵次數和降低損耗等。
-

炮泥用酚醛樹脂
炮泥用酚醛樹脂炮泥用酚醛樹脂具有可塑性好(hǎo)、殘碳量高、遇熱後(hòu)炮泥顯氣孔率低、粘附強度高、穩定性好(hǎo)等諸多優點,可以延長(cháng)出鐵時(shí)間,減少出鐵次數和降低損耗等。
-

魚雷罐磚用酚醛樹脂
魚雷罐磚用酚醛樹脂魚雷罐磚用酚醛樹脂是一種(zhǒng)熱固性高分子材料,具有抗熱震性好(hǎo)、抗侵蝕性強、不黏渣等特點,在魚雷罐和鐵水包上使用,能(néng)很好(hǎo)的滿足不同客戶的需要。
-

鋁碳化矽碳磚用酚醛樹脂
鋁碳化矽碳磚用酚醛樹脂鋁碳化矽碳磚用酚醛樹脂,不同的酚醛樹脂其化學(xué)組成(chéng)、分子量和聚合度等方面(miàn)都(dōu)可能(néng)有所不同,因此在使用時(shí)需要根據具體的使用要求和鋁碳化矽碳磚的工藝要求來選擇适合的酚醛樹脂。同時(shí),酚醛樹脂在使用過(guò)程中也可能(néng)釋放出有害氣體,因此需要采取相應的環保措施來控制其對(duì)環境的影響。
-

胎面(miàn)功能(néng)樹脂/抗撕裂樹脂/抗濕滑樹脂
胎面(miàn)功能(néng)樹脂/抗撕裂樹脂/抗濕滑樹脂胎面(miàn)功能(néng)樹脂/抗撕裂樹脂/抗濕滑樹脂等輪胎胎面(miàn)膠用功能(néng)樹脂是一類天然樹脂改性的芳香族樹脂, 與橡膠的相容性好(hǎo),具有良好(hǎo)的加工工藝性能(néng)。使用RT51**系列樹脂後(hòu)可有效提高輪胎胎面(miàn)的抗撕裂、耐切割性能(néng)和抗崩花掉塊性能(néng)使用;RT52**系列樹脂後(hòu)能(néng)顯著改善輪胎的抗濕滑等性能(néng)而不影響滾動阻力,同時(shí)具有優異的熱穩定性,對(duì)橡膠的硫化性能(néng)無影響。
-

濕簾紙用酚醛樹脂
濕簾紙用酚醛樹脂濕簾紙用酚醛樹脂是一種(zhǒng)能(néng)長(cháng)時(shí)間保證濕簾紙不出現白斑、易碎、發(fā)泡、彎曲等現象的優質樹脂。
-

PTV用樹脂硫化劑
PTV用樹脂硫化劑PTV中的樹脂硫化劑通常是一種(zhǒng)固體材料,其主要作用是吸附和捕獲樣品中的揮發(fā)性有機化合物,特别是硫化物。這(zhè)些樹脂硫化劑通常包含硫化合物,例如硫化鉛(lead sulfide)或硫化汞(mercury sulfide),這(zhè)些硫化合物具有吸附和濃縮目标化合物的能(néng)力。
-

絕緣材料用酚醛樹脂
絕緣材料用酚醛樹脂絕緣層壓材料用酚醛樹脂應用于絕緣、層壓材料的産品,具有工藝性良好(hǎo),其産品廣泛應用于絕緣闆、彩鋼闆,可根據客戶工藝要求進(jìn)行樹脂調整和開(kāi)發(fā)适應新工藝的樹脂。
-

切割片/盤式刹車片/鼓式刹車片/離合器面(miàn)片用酚醛樹脂
切割片/盤式刹車片/鼓式刹車片/離合器面(miàn)片用酚醛樹脂本系列液體酚醛樹脂主要應用于濕法生産摩擦材料、離合器面(miàn)等産品;樹脂具有分子量分布窄,指标控制嚴格等特點; 本産品具有高強度、加入量低的特點。
-

磨片用酚醛樹脂
磨片用酚醛樹脂磨片(Grinding Wheel)是一種(zhǒng)用于磨削、切削和研磨材料的工具,酚醛樹脂是常用的粘結劑之一,用于將(jiāng)磨料顆粒粘結在一起(qǐ),構成(chéng)磨片的切削表面(miàn)。
-

金剛石用酚醛樹脂
金剛石用酚醛樹脂金剛石用酚醛樹脂是一種(zhǒng)特殊的砂輪或切削工具,它將(jiāng)金剛石顆粒與酚醛樹脂結合在一起(qǐ),以制造高效的磨削和切削工具。
-

砂輪用酚醛樹脂
砂輪用酚醛樹脂砂輪網格布浸漬用樹脂- 固結磨具用酚醛樹脂,于砂輪網格布浸漬,包含熱塑(塊狀、粉狀、液體)、熱固(液體)兩(liǎng)種(zhǒng)類型,有很好(hǎo)的附著(zhe)力、柔韌、防粘連的特點。
-

覆膜砂用酚醛樹脂
覆膜砂用酚醛樹脂聖泉長(cháng)期緻力于覆膜砂酚醛樹脂的開(kāi)發(fā)和應用研究,不斷改進(jìn)覆膜砂酚醛樹脂的各項性能(néng),優良的綜合性能(néng)使其廣泛應用于各類鑄造領域。
-

XYLOK酚醛環氧樹脂
XYLOK酚醛環氧樹脂XYLOK酚醛樹脂-電子材料用酚醛樹脂特殊結構的高純度苯酚芳烷基樹脂,具有良好(hǎo)的力學(xué)性能(néng),化學(xué)穩定性好(hǎo),耐熱性高,耐水性好(hǎo), 硬化時(shí)收縮小,制品尺寸穩定等優良性能(néng)。



















